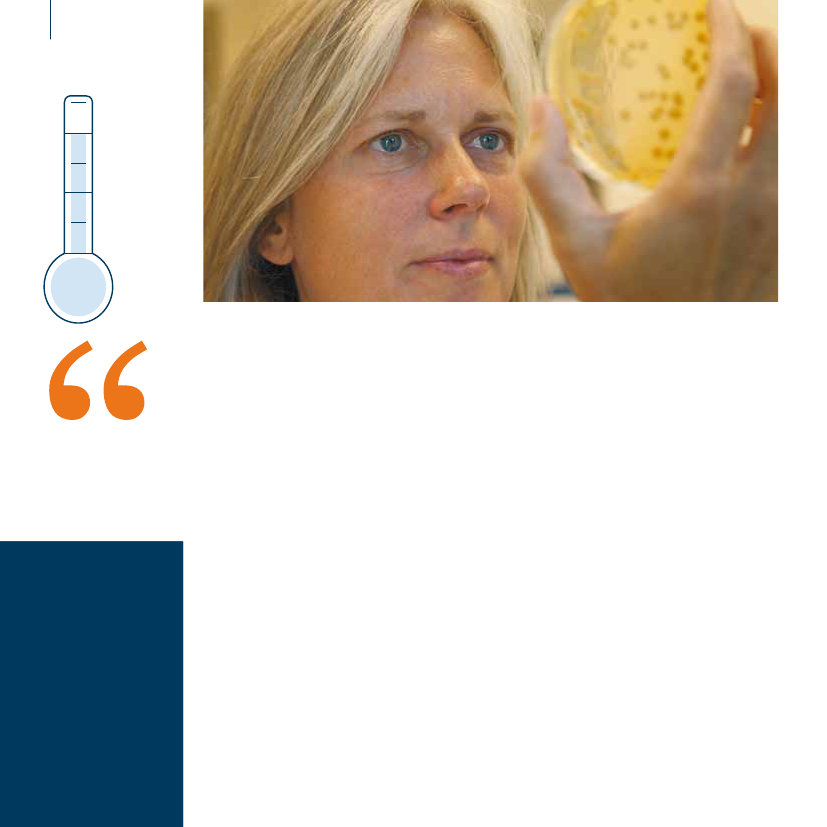

Det Energipolitiske Udvalg 2009-10, Udvalget for Videnskab og Teknologi 2009-10
EPU Alm.del Bilag 25, UVT Alm.del Bilag 18
Offentligt
EUDP støtterenergiteknologiske projekter•der styrker forsyningssikkerheden•mindsker udledningen af CO2•bidrager til realisering af Danmarksstore erhvervspotentialer på energiområdet
2Design og produktionMontagebureauet ApSwww.montagebureauet.dkTekstTextCompany,Vivian Skovbjergwww.textcompany.dkFotoFotograf Michael Jensenwww.world-photo.dkFoto omslagScanpixwww.scanpix.dkTrykKailow Graphic A/Swww.kailow.dkCO2-neutralproduktionCO2-udledningen vedproduktionen af denne op-gave er neutraliseret vedat støtte klimaprojekter, derresulterer i en tilsvarendeCO2-reduktionRedaktionEUDP, Dorthe Leander[email protected]Ansvarlig redaktørEUDP, Nicolai Zarganis[email protected]ISBN:978-87-7844-799-9ISBNwww:978-87-7844-801-9
3EUDP (Energiteknologisk Udviklings- og Demonstrati-onsprogram) bygger bro mellem forskning og marked ogstøtter op om hele udviklingskæden. I alle projekter er derfokus på, at resultaterne så hurtigt som muligt skal opnåudbredelse på markedet.
EUDP er med tre ansøgningsrunderpå halvandet år kommet rigtig godtfra start. Programmet har med sitklare kommercielle fokus opleveten meget stor efterspørgsel, ogansøgerne har indtil videre stilletmed egenfinansiering på omkring2 mia. kr. til de ansøgte projekter.Det vidner om, at der er sto-re kommercielle perspektiver fordansk energiteknologi, der styrkerforsyningssikkerhedenogmind-sker udledningen af CO2. Danskevirksomheder eksporterer nu ener-giteknologi for mere end 60 mia.kr. årligt, og der er potentiale tilyderligere stigninger i takt med den
stigende globale efterspørgsel efterenergi.Danmark tilfører i disse år be-tydelige nye offentlige midler tilforskning, udvikling og demonstra-tion af ny energiteknologi, og deter politisk besluttet, at der i 2010skal være 1 mia. kr. til rådighed iforskellige støtteprogrammer.EUDP vil gerne opfordre virk-somheder og universiteter til at gåsammen om at udvikle ambitiøseprojekter for ny energiteknologimed stort internationalt poten-tiale. På den måde kan vi sammengøre 2010 til et fantastisk år fordansk teknologiudvikling.
På de følgende sider er kort be-skrevet en række af de spænden-de projekter, som EUDP har støt-tet indtil nu. En komplet oversigtkan du finde på vores hjemme-sidewww.ens.dk/eudp,hvor duogså kan finde information og an-søgningsmateriale til kommendeansøgningsrunder.
Torkil Bentzen
Formand, EUDP
4Projekt:Udvikling af en modifi-ceret gærstamme, der kanudnytte C5-sukkertypen
Start:Juni 2008
3 årVarighed:3 år
2 år
1 årEUDP-tilskud:
11,25mio. kr.
Birgitte Rønnow, Terranol:”Terranols gær øger udbyttet af hver halmballe med 30 – 45 %.”
Gæret sukker giverny energiTerranol udvikler en modifi-ceret gær, som kan sætte heltnye standarder for udnyttel-sen af halm i produktion afbioethanol. EUDP-midlerne vilsende gæren direkte ind i entestfase, som kan blive afgø-rende for prisen på din benzinog verdens forsyningssikker-hed.Terranol blev etable-ret i 2007 af de trenuværende ejere,som alle har storerfaring i industri-el bioteknologi.Virksomheden harspecialiseret sig i ud-vikling af gærstam-mer til produktion afbioethanol på basisaf landbrugets over-skudsprodukter.
så det er et af de helt store brød,Terranol har fået EUDP-penge til at”bage”.På besøg i laboratoriet”Mennesker har i tusindvis af årbrugt gær til at producere brød,vin og øl – og gær er nem at ar-bejde med. Vi udnytter gærensrobusthed og stabilitet industri-elt ved at justere på dens styrkeog på det tidspunkt, dens effektkommer til udtryk i processen”,forklarer administrerende direk-tør Birgitte Rønnow. ”Vi er stadigi laboratoriet, men med EUDPstilskud er vi nu også i gang meden test, hvor vi forventer at do-kumentere gærstammens effekt.”En del af klimaløsningen”Langt størstedelen af al trans-port er i dag baseret på olie, og
transportsektoren står dermed foren meget stor del af den samledeudledning af drivhusgasser. Derforvil det kunne bidrage væsentligttil at løse klimaudfordringen, hvisvi kan knække C5-gåden og højneudbyttet af sukker fra halm med30 – 45 %, når vi i producererbioethanol. De mikroorganismer,som vi fremstiller i laboratoriet,kan også på længere sigt brugestil at omdanne halm og biomassetil plastik, nylon og kemikalier,som normalt også produceres afolie. Så den blåstempling af pro-jektet, som tildelingen af EUDP-midler betyder, støtter både herog nu – og rækker samtidig enhjælpendehåndtilfremtidensklima plus den fremtidige og bæ-redygtige forsyning med de mate-rialer og kemiske stoffer, som vihar brug for.”
Opfindelsen kansænke prisen påbiobrændstofmed 25 %
Enhver bager ved, at den rigtigegær er grundlaget for at kunneslå store brød op. Sådan er detogså med brændstoffet bioethanolproduceret af halm. Terranol ud-vikler en genmodificeret gær, derskal låse koden op til den ener-gi, der ligger gemt i de såkaldteC5-sukkerstoffer. C5 udgør ca. 1/3af sukkerindholdet i halm. Med dennye gær bliver energiudbyttet afhver halmballe 30 – 45 % større,
Projekt:Udvikling og demonstrationaf kommercielt koncept for om-kostningseffektiv energirenove-ring af boligbyggeri fra 1960´erneog 70´erne
5
Start:September 2008
3 årVarighed:3 år
Ditte VesteragerChristensenTeknologisk Institut
2 år
1 årEUDP-tilskud:
Ditte Vesterager Christensen, Teknologisk Institut:”Med renoveringen sparer boligerne 75 % på energiregningen.”
mio. kr.
5,5
Albertslundrykker op i energiklasseMange boliger fra 1960’erneog 1970’erne trænger til atblive renoveret. Lige nu te-ster Teknologisk Institut etnyt renoveringskoncept på nirepræsentativeprøvehuseiAlbertslund. Målet er at bringeboligerne op i højeste energi-klasse til en pris, der er kom-mercielt interessant.Hvis gråspurvene foretrækker atlune sig på naboens tagryg, er detsikkert fordi, dit hus er bedre isole-ret. Mange huse er ikke gode til atspare på energien, men det kan deblive, mener Teknologisk Institut.Filosofien er at udvikle standardele-menter og -moduler, der kan mas-seproduceres og installeres hurtigt.Solprisme på taget”En af de store udfordringer er atudvikle masseproducerbare løs-ninger, der både er tilstrækkeligtenergieffektive og økonomisk ren-table” forklarer projektleder DitteVesterager Christensen fra Tekno-logisk Institut. ”Danfoss, Velux ogRockwool har udviklet byggema-terialer og komponenter, som vikombinerer og tester i forskelligeløsninger, der også tilgodeser ar-kitekturen, æstetikken og funktio-naliteten. En af ideerne er et sol-prisme med integreret solvarme,solceller og ovenlys, som monte-res på taget. Målet med renove-ringen er at reducere boligernesenergiforbrug til lavenergiklasse 1eller bedre, hvilket betyder underen fjerdedel af forbruget i dag.De ni prøvehuse er forløberefor renovering af yderligere 2.300boliger i Albertslund. I Danmarker der bygget ca. 320.000 boligerFra Albertslundtil resten af verden?”Behovet for at spare energi fin-des i alle typer byggeri, så vi kansagtens forestille os, at koncep-tet senere bliver modificeret tilbrug andre steder – også uden forDanmark. Naturligvis fokuserer vipå teknologisk udvikling, men kli-maudfordringen og mulighedernefor at bidrage til Danmarks vækstligger os også på sinde. Støttenfra EUDP betyder, at der i et tætsamarbejde mellem byggemateri-aleproducenter, rådgivere og byg-herrer bliver udviklet energibespa-rende løsninger og koncepter, somellers aldrig havde set dagens lys.”Teknologisk Insti-tut har indgået etsamarbejde med enrække kommerciellepartnere med hen-blik på udvikling,demonstration ogkommercialiseringaf konceptet.
af denne type i perioden 1960-1979, så perspektiverne er til atfå øje på.”
Bygninger står for40 % af vores sam-lede energiforbrug
6
Lampen af plast-solceller kosterca. 5 USD at frem-stille og kan lysei op til seks timerefter en halvtimes opladning
Solenergitrykt på plastikRisø DTU har udviklet verdensførste solceller, som er 100 %plastik. De er effektive, de kantrykkes på en almindelig tryk-kerimaskine, og prisen er væ-sentlig mindre end prisen forde eksisterende silicium-solcel-ler. Derfor har projektet indu-strielt potentiale, og Risø DTUmener selv, solcellebranchenstår foran et nyt industrieven-tyr, der kan sammenlignes med1990’ernes vindmølleeventyr.Solen er den vedvarende ener-gis moder. Solen giver liv, lys ogenergi – og det er logik, at tek-nologien jagter muligheder for atlagre solens energi og gøre den tilen del af den almindelige energi-forsyning. Risø DTU er langt i den-ne jagt. Deres nye plastsolcellerkan måske blive en af fremtidensteknologier, som for alvor levererstrøm baseret på en vedvarendeenergikilde.Du kender solceller fra have-lamper, lommeregneren og nød-telefonernepåmotorvejen.Atsolcellerne endnu ikke har fåetindustrielt gennembrud, hængerførst og fremmest sammen medprisen. Celler af silicium kosterca. 5.000 kr. for en kvadratmeter,men en solcelle af plastik kan nåpriser på under 100 kr. Samtidiger plastcellerne betydeligt mereeffektiveendsilicium-cellerne,fordi plast leder sollysets energimeget bedre.Print en lampeFrederik Krebs er seniorforsker påRisø DTU og har forsket i plastsol-cellerne siden 2001. ”Plast er detideelle materiale at arbejde med.Detfåsgennemsigtigt,hvilketdesignmæssigt kan være en for-del. Det er let og smidigt, så manreelt kan forme hvad som helst.Det er stabilt at arbejde med i enproduktion – og det er kendt tek-nologi. Den aktive trykfarve, somomsætter sollys til energi, er detnye – og det videntunge i projek-tet. Der skal i alt fem lag flydendetryksværte på, og resultatet er enplastsolcelle, der efter en halv ti-mes opladning af et batteri i so-len kan få en lysdiode til at lyse iseks timer. Populært sagt kan vi
7
Risø DTU er national-laboratoriet for bæredyg-tig energi ved DanmarksTekniske Universitet, DTU.Risø DTU er kendt for storestrategiske forsknings-og udviklingsopgaver ogforskning på internationaltniveau.
Frederik Krebs, Risø:”Risø DTUs patenterede trykfarve errecepten på CO2-fri strøm fra sollys.”
printe en lampe, hvilket faktisker lige præcis det vi gør. Vi prin-ter plastsolceller i A-4 format, derkan samles til en lampe, som ertilstrækkeligt læselys. Lampen te-ster vi i øjeblikket i Zambia. Vi vilgerne give lys til afrikanske børn,så de kan lære at læse. På denmåde støtter vi en god sag, somer kombineret med en videnska-belig test og dokumentation medhenblik på industrialisering gen-nem EUDP-projektet.”Bro mellem forskningog industriPlastsolcellen er et godt eksempelpå et udbytterigt forsknings- ogindustrisamarbejde,derfrem-mer den teknologiske udvikling.
De seneste fem år har Risø DTUsamarbejdet med Mekoprint Elec-tronics, der har udstyr, som gørindustriel masseproduktion mu-lig. Risø DTUs tryksværte blivertrykt på store plastruller ligesomrotationstryk af dagblade og an-dre tryksager med volumen. GaiaSolar A/S, som er kendt for sol-cellepaneler,testerRisøDTUsplastsolceller på store paneler, derproducerer strøm til elnettet. OgdesignvirksomhedenFAKTOR3sikrer, at lyset også ser godt ud.”Midlerne fra EUDP bliver for-delt på alle fire involverede virk-somheder. Pengene kan betalei alt fem ansatte, så ud over atdrive plastsolceller gennem dennevigtige testfase, bidrager støtten
også til udvikling i de involveredevirksomheder” forklarer FrederikKrebs og understreger: ”EUDP-støtten bringer projektet op i enhøjereskala,undersøgelsernebliver bedre, og vi får dokumen-tation til den helt rigtige industri-proces, som skal implementereplastsolceller i verdens energifor-syning. Uden støtten ville Dan-mark ikke være med helt fremmei den globale konkurrence om etgennembrud for konvertering afsollys til elektricitet uden at for-urene eller bidrage til drivhus-effekten. En konkurrence, hvorpræmierne både er bedre klima,flere arbejdspladser og en storøkonomisk gevinst.”
Projekt:Test og dokumentationaf plastsolceller medhenblik på industriali-sering
3 årStart:1. juli 2009Varighed:2 ½ år
2 år
1 årEUDP-tilskud:mio. kr.
9,9
8
Tilsagn om EUDP-midler 2008*fordelt på teknologiområder1.000 kr.35.00030.00025.00020.00015.00010.0005.0000
Deltagere i EUDP-projekter 2008**fordelt på størrelse af virksomheder
Universitet17%Stor37%Mikro20%
lerktiviteBøtlgeenergiBiomasse
Bræ
En
er
/GAnasv.FossEnileergilagringSystemer
effe
nd
Mellem-stor9%
sel
gi
O
lie
Ø
Lille17%
Brin
So
ndVi
scel
vrig
e
t
l
Tilsagn om EUDP-midler 2008**fordelt på størrelse af virksomheder1.000 kr.800.000700.000
Ansøgt beløb ogafgivne tilsagn 2008*
Gennemsnitligtilsagnsstørrelsepr. projekt:3,4 mio. kr.
Stor18%
600.000
Universitet26%
500.000400.000
Mellemstor9%Mikro17%Lille30%
300.000200.000100.0000AnsøgtTilsagn
* Ekskl. særlig pulje til 2G bioethanol** Ekskl. kommuner og statslige organisationer
NB: Opdeling på virksomhedsstørrelse er foretaget efter EU’s definition på virksomhedsstørrelse af 6. maj 2003 (K(2003) 1422).
9FredensborgHillerødAllerødFrederikssundHørsholmFuresøEgedalLæsøRoskildeGladsaxeHerlevBallerupKøbenhavnAlbertslundThistedAalborgRebildMariagerfjordSkiveRandersStruerHolstebroViborgFrederiksberg
HjørringFrederikshavn
HvidovreIshøjVallensbækDragør
EUDP-projekter2008HelsingørHalsnæsFredensborgHillerødHørsholmLyngby-TaarbækGentofteSamsøOdsherredEgedal
HerningRingkøbing-Skjern
Silkeborg
Århus
Ikast-Brande
Skanderborg
Horsens
Billund
Vejle
HedenstedKalundborgFredericia
Høje Taastrup BrøndbyLejreGreveDragør
Esbjerg
Vejen
Kolding
Middelfart
KertemindeOdenseSlagelseNyborgNæstved
KøgeStevns
AssensHaderslev
Aktive EUDP-projekterspredt over hele DanmarkEUDP gav i 2008 tilsagn om tilskud tilnæsten 50 større projekter inden for nyenergiteknologi. På kortet er angivet,hvor lederen af disse projekter holder til.Endvidere deltager en lang række andre
TønderAabenraaSønderborg
Svendborg
Vordingborg
ÆrøLolland
virksomheder og institutioner.
2G bioethanolBiomasseBrintBrændselscellerBølgekraftEffektiv energianvendelse
EnergibesparelseEnergilagringFossile brændslerLagringSolenergi (sol og sollagring)Vindenergi
10
Bioethanol frahalm reducererCO2udslippetmed 85 % sam-menlignet medbenzin
Michael Persson, Inbicon A/S:”Hvis 10 % af Danmarks benzinforbrug erstattes med Inbicons ethanol, reducerer vi CO2udslippet med 600.000 ton om året.”
Kør påhalmballerogskån miljøetDen DONG-ejede virksomhed Inbicon A/S er global innovatørinden for udvikling af bæredygtig energi. Med en patenteret tek-nologi og proces muliggør de konverteringen af biomasse til høj-værdiprodukter – herunder bioethanol – på et niveau, der åbnermulighed for en international, kommerciel succes. Sidegevin-sten er en betragtelig klimamæssig effekt.Danmark er et landbrugsland medstolte traditioner, og vi skal ikkelængere tilbage end til 1930-erne,før mere end halvdelen af befolk-ningen var beskæftiget med land-brug.Du kender synet af de mangesensommermarker,hvoråretskornhøst har efterladt halmstrå-ene. For år tilbage brændte en dellandmænd halmen af, bl.a. fordider ikke var stor efterspørgsel pådette restprodukt. Markafbræn-ding blev i 1989 forbudt af miljø-mæssige årsager, og netop halmer i dag Inbicons vigtigste råstof.Deres store biomasseanlæg i Ka-lundborg vil blive fodret med 4 tonhalm pr. time, og det årlige udbyt-te bliver: 5,4 mio. liter bioethanol,8.250 ton bio-brændselspiller og11.000 ton C5-melasse.Ved bioethanolproduktion vilder altid opstå værdifulde restpro-dukter, menforklaringen på, atInbicon producerer andet end bio-ethanol, finder vi i deres grundfilo-sofi: ”Vi vil omdanne biomasse tildet, der sammen med bioethanolgiver mest værdi” siger InbiconsVice President Michael Persson.”Vores mål er ikke nødvendigvis atproducere så meget ethanol sommuligt, men at omdanne biomas-sen til det, der giver mest værdi iforhold til det sted, hvor produkti-onsanlægget ligger.Her på demonstrationsanlæg-get i Kalundborg har vi valgt, atvi ikke vil bruge alle sukkerstof-ferne fra halmen til ethanolpro-duktionen, fordi teknologien tilomdannelse af det såkaldte C5-sukker lige nu er for usikker i såstor skala, som vi arbejder i. Detlevner i dag en stor portion C5-sukkermelasse, der fx kan brugestil dyrefoder og dermed kommeretur til landmanden eller brugessom tilsætning til biogasproduk-tion. Vi vil løbende overveje, omC5-sukkeret i stedet skal omsæt-tes til ethanol.Alene de brændselspiller, somvi også producerer af halmen i
11
Inbicon A/S er et datter-selskab af DONG EnergyA/S. Selskabet er opret-tet for at videreudvikleog kommercialisere denteknologi, som omdannerbiomasse til bioethanol,biobrændsel og C5-melasse. En teknologi,der er udviklet hos DONGEnergy siden 2003.
samme proces, indeholder mereenergi, end der anvendes i demon-strationsanlægget. På den mådeer anlægget mere end selvforsy-nende med energi, og de over-skydende brændselspiller kan visælge.” Yderligere to faktorer ermed til at effektivisere energiud-nyttelsen. ”Vores teknologi arbej-der med et tørstofindhold på op til40 %, hvilket sparer 59 % damp og32 % el. Og så ligger vi ved sidenaf Danmarks største kraftværk,Asnæsværket, som leverer over-skudsdamp til os.”Patenteret procespå vej til USA?Når halmen kommer ind i produk-tionsanlægget, skal den gennemen lang proces baseret på Inbiconssærlige ekspertise. ”Første trin eren trykkoger, hvor vi nedbryder
halmens fibre. Næste trin er dentank, hvor vi gør halmen flydendeog frigør sukkerstofferne. Underhele processen arbejder vi med sålidt vand som muligt, for det spa-rer energi til opvarmning, transportog udskilning. Samtidig tilsætter viikke syrer eller andre aggressivestoffer, hvilket har en god miljø-mæssig effekt, og tilmed behøvervores produktionsapparat ikke atvære lavet af det mest modstands-dygtige og dermed dyre stål.”Demo-anlægget i Kalundborger et led i et langt, sejt træk, hvorman går fra laboratorieskala overpilotanlæg og demonstrationsan-læg til industriel skala. Med EUDP-midlerne kommer Inbicon op på4 ton halm pr. time, og netop detskridt er afgørende for kommer-cialiseringen, mener Michael Pers-son. ”Ny højrisikoteknologi kræver
væsentlige investeringer – isærnår man kommer op i nærhedenaf industriel skala. Pengene hargjort det muligt for DONG at op-skalere denne satsning, som for-håbentlig viser sig at være et stortteknologisk miljøgennembrud. Vivil gerne bidrage til den overord-nede forsyningssikkerhed ved atbruge den hjemlige råvare halm istedet for olie. Endelig er vi medtil at gavne beskæftigelsen både iproduktionen på vores fabrikker, ilandbruget og i den transportsek-tor, der skal transportere halmen.”Inbicon har markedsstrategi-en klar. ”Vi vil gerne sælge voresteknologi til hele verden, men detstørste potentiale findes i USA,hvor man er meget målrettet in-den for biobrændstoffer og har debedste incitamenter.”
Projekt:Opførelse af anlæg tildemonstration af2. generations bioetha-nol-produktion medhenblik på kommercia-lisering
3 år
2 årStart:Juni 2008Varighed:1 ½ år
1 årEUDP-tilskud:mio. kr.
54,2
12
1/3 af verdens elkan i fremtidenkomme fra bølge-energiProjekt:Endelig test af 500 kWbølgekraftmaskine medhenblik på masseproduktion
Bølgekraft medinternationaledønningerWave Star Energy står forantest af en 500 kW bølgekraft-maskine, som kan blive et in-ternationalt gennembrud fordansk bølgeenergi. Som deneneste af sin art i verden liggerden i havoverfladen, hvor densfangarme optimerer energiop-74 meter langt badedyrmed 40 arme”Der er hele fire unikke faktorer”fortæller teknisk direktør LaurentMarquis. ”Først og fremmest, atanlægget flyder på vandet, hvilketer en fordel mekanisk og vedlige-holdelsesmæssigt. Dernæst hy-draulikken, som konstant regule-rer armenes tryk på vandet ud fralogikken: Jo mere vandmodstandForestil dig, at du træder vande. Jostørre armbevægelser des størrevandmodstand. Præcis denne ef-fekt udnytter Wave Star Energydes mere energi. Armenes samar-bejde er også en unik faktor. Deudnytter hele bølgen ved at bear-bejde den på vejen gennemmaskinen. Fjerde unikke faktor eren autopilot, der måler vand- ogbølgehøjde, så maskinen hæverog sænker sig i takt med vandetog derved holder en konstant pro-
Wave Star Energy A/Sblev etableret i 2003 oger blandt verdens føren-de inden for udvikling afbølgeenergi.
duktion. Fangarmene sender denindsamlede energi til en hydrau-likmotor, der er forbundet medgeneratoren,strømmen.”Ligger til det danske højrebenDanmark har erfaring inden foroffshoreogskibsfart,ogvo-res kystlinje mod Nordsøen erideel til bølgekraft. Derfor liggerdet til højrebenet, at vi scorer før-stepladsen inden for bølgeener-giteknologi.”Detinternationalepotentiale er iflg. engelske CarbonTrust 2 - 4.000 TWh om året, hvil-ket svarer til 1/3 af verdens elfor-brug. For at komme dertil, skalvi i denne test bevise, at vi kanudnytte 80 % af demo-maskinenseffekt på 500 kW. Vi forventer atdokumentere, at maskinen funge-rer stabilt og giver løfte om øgeteffektivitet. Støtten fra EUDP øgerhelt sikkert både udviklingshastig-heden, åbner døre til andre inve-storer og højner chancen for, atDanmark bliver først og førendeinden for bølgeenergi.”somproducerer
3 årStart:2. kvartal 2009
samlingen med deres svømme-bevægelser.
2 årVarighed:2 år
1 årEUDP-tilskud:mio. kr.
i verdens første seriefremstillede500 kW bølgekraftmaskine til åbenthav. Resultatet er bedre udnyttelseaf bølgekraft, end verden nogen-sinde har set.
20
Laurent Marquis,Wave Star Energy:”Bølgekraftmaskinen på 500 kW kanforsyne 500 husstande med strøm.”
13Center for Elteknologi på DTU har indgåetsamarbejde med Ea Energianalyse, Vestfrost,Danfoss og Østkraft med henblik på demon-stration og industrialisering af teknologien.
Projekt:Demonstration af teknologi til regule-ringen af elnettets frekvens via elek-triske apparater og installationerStart:April 2009
3 årVarighed:3 år
Jacob Østergaard, DTU:”Den nye teknologi regulerer frekvensen til underhalv pris af de metoder, vi kender i dag.”
Styring af elnettetsfrekvens uansetvindstyrke erafgørende for atnå målet om 50 %vindenergi i 2025
2 år
1 årEUDP-tilskud:mio. kr.
Strømsom vinden blæserBalance mellem produktionog forbrug er visionen forenhver virksomhed. Når pro-duktet er strøm fra vindmøl-ler, er balancen ekstra svær,men stabil frekvens er vigtigfor at undgå strømnedbrud.Ved at højne intelligensen islutbrugernes elektriske ap-parater mener DTU Elektroat have fundet et simpelt,billigt og effektivt bidrag tilat sikre jævn frekvens ogdermed plads til flere vind-møller i elsystemet.Køleskabet holder konstant dinmælk på 5 grader, og gulvvar-Kloge køleskabepå Bornholm”Det er en ganske simpel chip,som bliver installeret i appara-terne, så de konstant måler net-tets frekvens og tænder/slukkeri takt med udsving” forklarerDanmark med i front”Uden midlerne fra EUDP varprojektet ikke blevet realiseret.Men nu er Danmark med helt imen i badeværelset kan du ogsåprogrammere til en fast tempe-ratur. Det kræver intelligent tek-nologi at kunne holde den fastetemperatur og samtidig sikrebåde balancen og en stabil fre-kvens i elnettet. Vindstyrken erumulig at styre, så derfor er derstort behov for styring af andreled i elsystemet.professor Jacob Østergaard fraDTU. ”Mælken og badeværel-sesgulvet bevarer den konstantetemperatur, og forbrugernes ap-parater hjælper med at afbalan-cere hele elsystemet. Vi testerteknologien på Bornholm, hvornettet kan isoleres i ødrift, så vikan gennemføre præcise analy-ser af effekten. Her installerer vichip´en i 200 enheder – fx gulv-varmeanlæg og flaskekøleskabei supermarkeder.”
5
front og har et forspring i kam-pen om at levere teknologi til englobal løsning med internatio-nale standarder. Den nye tekno-logi bidrager simpelt og billigt tilat øge integrationen af vedva-rende energi, og elnettet blivermere pålideligt og sikkert, så vilettere undgår nedbrud. Endeliger der de kommercielle aspek-ter i form af industriel vækst ogarbejdspladser”understregerJacob Østergaard, der ser storeperspektiver i den nye tekno-logis bidrag til frekvensregule-ring.
14
Mikael Sloth, H2 Logic:”En brintdrevet truck kanspare CO2svarende tilotte personbilers udledning.”
Brint + luft =strøm udenudskilning afpartikler ellerCO2
Brint + luft= ren muskelkraftEn truck kører på enten die-sel, LPG-gas eller batteri. Detbehøver de ikke længere, nårH2 Logics endelige afprøvningaf brintdrevne trucks er gen-nemført. Fordelen for slutbru-geren er mere drivkraft, hurtigoptankning, højere effektivitetog renere luft. Klimamæssigter det ultimative perspektiv100 % bæredygtig drift.BæredygtigMennesker, dyr og planter harbrug for luft og vand for at leve.Men at en truck kan køre på enblanding af luft og brint, og atdens eneste udstødning er drikke-klart vand, er næsten for godt tilat være sandt. Det er ikke destomindre virkelighed, når truckenkører på brændselsceller – enslags gas-drevet batteri.elektrisk transport”Visionen er 100 % CO2-fri drift,som er mulig, hvis brinten bliverproduceret af vedvarende energisåsom vindmøller”, siger forret-ningsudviklingschef Mikael Sloth.”Her og nu kan vi love trucks, derhverken udskiller partikler ellerCO2, hvilket kommer til at placeredem i en helt anden klimaliga endNår en brændselscelle bliver forsy-net med brint og luft, producererden elektricitet. Brinten kommerfra et gasselskab og bliver tanketligesom benzin, luften kommer fraomgivelserne – og resultatet er etkøretøj, der hverken udskiller par-tikler eller CO2. Kun en lille smulevand, som fordamper eller blivertil et par dråber på gulvet.traditionelle dieseltrucks. En al-mindelig truck udskiller årligt optil 27 tons CO2, mens en personbiludskiller 3,3 tons. En brintdrevettruck kan med andre ord spareklimaet for CO2svarende til ottepersonbiler. Samtidig får truckenstørremeddrivkrafttraditionellesammenlignetbatteridrevne
trucks, som ofte bliver fravalgt afslutbrugeren. Pointen er, at vi bru-ger brint og luft i en brændsels-celle, som er monteret i truckenog producerer elektricitet til frem-driften. Vi har designet systemetmed henblik på at optimere ener-gieffektiviteten og gøre systemetså simpelt og billigt som muligt.Sauer Danfoss ApS bygger denelektriske platform i trucken, somvi bygger vores brændselscelleind i, og vores samarbejdspart-
15
H2 Logic blev etablereti 2003 og har siden posi-tioneret sig som en afverdens førende udviklereaf brændselscellesystemertil køretøjer samt brint-optankningsstationer.
ner Dantruck A/S har opbyggetde trucks, vi tester systemet på.Så der er tale om et stærkt dansksamarbejde.”Testes i hele EuropaH2 Logic er i gang med at findede omkring 25 slutbrugere, derfår mulighed for at teste de brint-drevne trucks. ”Vi har valgt etrepræsentativt udsnit af produkti-ons-, logistik- og lagervirksomhe-der i hele Europa”, fortæller MikaelSloth og fortsætter: ”Udviklingenaf den brintdrevne truck har løbetover flere år. EUDP har støttet desenere trin i udviklingen og harmuliggjort denne afgørende test,som er fundamentet for kommer-ciel udbredelse.”DTU følger udviklingen og te-sten hele vejen for at udnytte re-
sultaterne i fremtidig forskning,og H2 Logic stiller brugerne storeresultater i udsigt. ”Rent praktiskfår trucken en mere fleksibel an-vendelse. Dieseltrucks må ikke ar-bejde indendørs, så i dag skal god-set lastes om fra udendørstruck tilindendørstruck, som kører på tra-ditionelt batteri. Det siger sig selv,at det sparer meget tid og lettertransporten, når trucken kan kørebåde ude og inde. Tid til batteri-skift sparer man også. Nuværen-de batterier skal lades op og skif-tes, og batteriskift i en stor trucker besværligt og langsommeligt.En brintdreven truck skal blot tan-kes op med brint, hvilket tager fåminutter ligesom en dieseltruck.Desuden udnytter brændselscel-len energien op til dobbelt så godtsom forbrændingsmotoren i en
dieseltruck. Den fordoblede ener-giudnyttelse forventer vi os ogsåmeget af, for det gør det muligt atkonkurrere på brændstofomkost-ningerne.”Mikael Sloth vurderer, at detårligeverdensmarkedforgaf-feltrucks er 150 mia. kr. ”Voresmarked er både klodens klimaog slutbrugerne. I omvendt ræk-kefølge. For hvis man ikke sikrerindustrialisering og salg af ener-giteknologiske opfindelser som fxbrintgaffeltrucken, så kommer dejo ikke ud og betyder den forskel,de potentielt kan være for klimaet.National opbakning i form af detteEUDP-tilskud er et vigtigt afsæt,som kan være med til at tiltrækkeyderligere midler til gavn for kom-mercialiseringen.”
Projekt:HyLIFT-DEMO –endelig demonstra-tion og dokumenta-tion af brintdrevnetrucks med henblikpå kommerciel ud-bredelseStart:Juni 2009Varighed:3 ½ år
3 år
2 år
1 årEUDP-tilskud:mio. kr.
2,9
Hvis du skal i gang med et spændende projekt inden for udvik-ling eller demonstration af en helt ny energiteknologi, kan dumåske få støtte fra EUDP. Du kan altid finde ansøgningsmate-riale og anden information om kommende ansøgningsrunder påEUDPs hjemmeside:www.ens.dk/eudp.
EUDP Sekretariatet
n
Energistyrelsen
n
Amaliegade 44
n
1256 København K
n
Tlf. 33 92 67 00
n
n
www.ens.dk